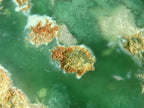
Polished One Side Polished Emerald Mtorolite Plates  x 2 From Zimbabwe - Toprock Gemstones and Minerals

Welcome to TOPROCKS.COM - You are shopping on our RETAIL site for worldwide customers and collectors. You are welcome to Shop and Ship any of our 20,000+ specimens with no minimum requirements. For WHOLESALE access, please Login using your 'Approved Wholesale / Trade' email address (HOW?) or email Renate@Toprocks.com
Skip to product information

Grade = Very Good Grade
Size = 146 - 198 mm | 5.7 - 7.8 inch
Net Weight = 1.1 Kg | 2.3 Lbs
Product Type = Small Batch

Polished One Side Polished Emerald Mtorolite Plates x 2 From Zimbabwe
MTOP1RO144741
RETAIL PRICE
R2,195.20 ZAR
Sale price
R2,195.20 ZAR
Regular price
AVAILABILITY: We currently have 1 in stock
PRODUCT INFORMATION
General Description
Mtorolite, an exquisite masterpiece of nature exclusive to the rich landscapes of Zimbabwe. Known as Chrome Chalcedony, Mtorolite shares the captivating allure of Chrysoprase while boasting its own unique charm. Its captivating green hue is not merely a colour—it's a symphony of light and chemistry. Chromium infuses vibrant shades into Chrome Chalcedony, while Nickel bestows Mtorolite with its distinct tone, sometimes adorned with delicate black Chromite specks. Each piece of Mtorolite is a natural work of art, emerging from intricate, plate-like deposits that bear the marks of time, appearing etched and weathered in their raw splendour. At Toprock, we pay homage to this natural elegance by meticulously polishing one side of the Mtorolite to reveal its lustrous sheen, while preserving its original form on the other side—whether it's the semi-crystalline botryoidal structures or a raw, untouched face. Though abundant in stock, our Mtorolite remains a hidden treasure awaiting its rightful place in the world of luxury and adornment. Slices and other polished forms of this exquisite material are exceedingly rare, but when available, they are nothing short of extraordinary due to the intrinsic nature of the stone. Our in-house polishing ensures that each piece meets the highest standards of craftsmanship. Price is grade dependant. Items are as shown.Product Data
Locality = ZimbabweGrade = Very Good Grade
Size = 146 - 198 mm | 5.7 - 7.8 inch
Net Weight = 1.1 Kg | 2.3 Lbs
Product Type = Small Batch
PRODUCT WEIGHT: 1.06 kg